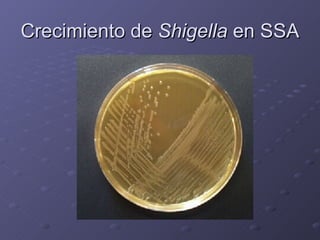
Crecimiento de  Shigella  en SSA

El documento proporciona información sobre las enterobacterias. Brevemente describe que son bacilos gramnegativos que se encuentran en el suelo, agua y alimentos. Incluye 20 géneros asociados con patología humana como Escherichia coli, Klebsiella, Proteus, Enterobacter, Serratia, Citrobacter, Salmonella y Shigella. Explica características morfológicas, bioquímicas, factores de virulencia, patologías asociadas y métodos de diagnóstico para algunos de estos géneros